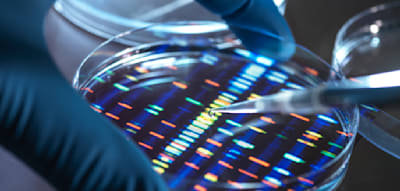
Warum auch 25 Jahre nach der Genom-Entschl&uuml;sselung viele Fragen offen bleiben

Ich bin mit 130 km/h um die Kurve gedonnert, damit Sie es nicht tun müssen
Zugang zu stern+
statt 11,96 € nur 1 €
- Alles von stern+ mit erstklassigen Inhalten von GEO und Capital
- 4 Wochen testen, dann 2,99 € je Woche
- jederzeit kündbar
Bereits registriert?
- Olympia
- Bobfahren
- Olympische Spiele
- Sport
- Selbsttest
Haftungsausschluss: Das Urheberrecht dieses Artikels liegt bei seinem ursprünglichen Autor. Der Zweck dieses Artikels besteht in der erneuten Veröffentlichung zu ausschließlich Informationszwecken und stellt keine Anlageberatung dar. Sollten dennoch Verstöße vorliegen, nehmen Sie bitte umgehend Kontakt mit uns auf. Korrektur Oder wir werden Maßnahmen zur Löschung ergreifen. Danke